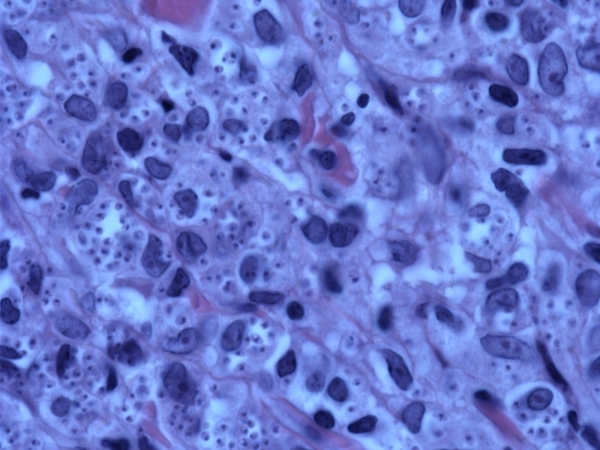

A lichenoid infiltrate that surrounds eccrine glands is seen in:
1 Lichenoid drug rection
2 Lichen striatus
3 Lichen planus
4 Lichenoid purpura
5 Lichen planopilaris

Lichen striatus is an uncommon inflammatory dermatitis seen most commonly in children aged 5 to 15.
It presents unilaterally along Blaschko’s lines as raised, slightly scaly, erythematous papules, which are often pruritic. These lesions typically regress spontaneously within a year.
The histopathologic features of lichen striatus include a superficial perivascular inflammatory lymphohistiocytic infiltrate with rare plasma cells and eosinophils.
There is a focal lichenoid infiltrate in the papillary dermis with basilar vacuolar alteration and necrotic keratinocytes.
Spongiosis with exocytosis of lymphocytes can be seen in the epidermis.
A specific and distinctive feature** of lichen striatus is the presence of an **inflammatory infiltrate that surrounds hair follicles and eccrine glands.
Epidemiology
Presentation
Prognosis and treatment
Histology
Lichen striatus. Erythematous scaly papules in a linear distribution on the thigh
Lichen striatus. Obliquely cut section. There is marked hyperkeratosis with parakeratosis, acanthosis, inflammation, and pigment incontinence
Lichen striatus. This field highlights the massive pigment incontinence.
Lichen striatus. There is a dense dermal lymphohistiocytic infiltrate

Comma-shaped bodies are seen in:
1 Benign cephalic histiocytosis
2 Malakoplakia
3 Sarcoidosis
4 Lipoid proteinosis
5 Gaucher’s

Benign cephalic histiocytosis
Comma-shaped bodies and worm-shaped bodies can be seen in a variety of histiocytoses and are non-specific. The most common association is with benign cephalic histiocytosis
S-100 (-)
CD1a (-)
CD68+
Factor XIIIa +

This tumor was excised from a verrucous yellow plaque on the scalp what is it?
1 Syringocystadenoma papilliferum
2 Eccrine acrospiroma
3 Hidradenoma Papilliferum
4 Tubular apocrine adenoma
5 Syringofibroadenoma

Syringocystadenoma Papilliferum: 33% arise in association with a nevus sebaceous, 10% may coexist with a BCC or trichoblastoma. A subset of cases has a deletion of 9q22 PTCH gene and 9q21 (p16). Histologically they present as surface invagination of glandular cords composed of one to two layers of cuboidal cells associated with a fibrovascular stroma with numerous plasma cells. Cystic spaces may form within which are free floating islands which are peripherally lined by cuboidal cells with an inner core composed of loose connective tissue, blood vessels and numerous plasma cells.
Fig 1 Syringocystadenoma papilliferum. Characteristic low-power morphology of a squamous epithelial border enclosing tall papillary projections with a dense infiltrate within their cores.
Fig 2 Syringocystadenoma papilliferum. The epithelium is double layered and the underlying stroma is rich in plasma cells.
Fig 3 Syringocystadenoma papilliferum. Superficially, the double-layered apocrine epithelium is replaced by squamous epithelium
Pathology
Histology
Immunopathology/special stains
Main differential diagnoses
Dr Giam Yoke Chin
Senior Consultant
National Skin Centre
Introduction
Papular eruptions occurring on healthy children’s faces can be puzzling. There are many possible causes e.g. milia, comedones, molluscum contagiosum, xanthogranuloma. In 1971, Gianotti described a condition called “Benign Cephalic Histiocytosis”. This is a self-healing eruption of yellow brown papules, occurring characteristically on the face of children. As the name suggests, in this condition, benign looking histiocytes accumulate on the facial skin of children. The cause is unknown.
Clinical features
5 cases were seen from 1988 to 1993 in National Skin Centre. They include 3 Chinese, 1 Indian and 1 Malay. These children were aged three to twenty-four months, with multiple 2 to 3 mm size papules, of yellow, brown and skin colour. All occurred on the cheeks, forehead and eyelids (Fig. 1 & 2).
Two of them had extension to the trunk and limbs. Three children had the diagnosis confirmed on histology. Two declined biopsy. The children were well with no evidence of organomegaly.
Benign Cephalic Histiocytosis**: **Clinical**: Face w/ Yellow, brown papules **Histology**: Benign histiocytes. Giant cells occasionally. **Ultrastructure: Comma-shaped bodies. S-100 (-)
Histiocytosis X:** Yellow brown papules with strongly adherent scaly crusts. Scalp, trunk, mucous membrane. **Histology: Large histiocytes with kidney-shaped nuclei. Infiltrate invades the epidermis. Ultrastructure: Birbek granules. S-100 (+) Treatment: Chemo
Investigations including: full blood count, serum cholesterol, triglyceride, and liver function tests were normal. Many improved within 6 months.
Discussion
Doctors have to be aware and be familiar with this histiocytosis as it is benign and self-limiting. The eruption are flat-topped, on the face (especially upper cheeks), but
can extend to the back of ears, arms, posterior neck (Fig. 3), thighs and buttocks.
Mucous membrane, palms, soles and viscera are spared. It regresses within 6 months to leave brown macules. These heal without scarring after one to a few years. The features differentiating Benign Cephalic Histiocytosis and Histiocytosis X are summarized in Table 1.
Histology, Immunology, Electron-Microscopy
The histiocytes are benign, though some show pleomorphic nuclei; with prominent nucleoli and scanty chromatin (Fig. 4).
Older lesions may show multinucleated giant cells [4,5]. They react with OKMI and Leu M3 monoclonal antibodies. SlOO-positive cells are absent. Ultrastructurally, about 20% of the histiocytes have comma-shaped bodies in their cytoplasm. These consist of two electron dense membranes of 60A1 separated by a space of 80A’. Birbeck granules seen in Histiocytosis X are not found.
Conclusion
This is another newly described disorder of the histiocytic Syndromes in children. It is important to be aware of: this condition, to avoid over-investigation and treatment of a benign condition.
The predominant location of the cleft in cicatricial pemphigoid is:
1 Dermal
2 Basment membrane zone
3 Basal keratinocytes
4 Supra basal
5 Subcorneal/granular

Basment membrane zone
Cicatricial pemphigoid is an autoimmune blistering disease that presents with ulcers, blisters and erosions of mucosal surfaces, especially the eyes and mouth. The cleft in cicatricial pemphigoid is found in the basement membrane zone/subepidermal as the antigens are usually BPAg2,laminin 5 and alpha-6-beta-4 integrin. Direct immunoflourescence is identical to that of bullous pemphigoid showing linear IgG and complement deposits in the basement membrane zone.
Pathology
Histology
Immunopathology/special stains
Main differential diagnoses
Fig 1 Mucosal pemphigoid. Note the intense erythema with erosion, features of desquamative gingivitis.
(Courtesy of J Nunley, MD; Virginia Commonwealth University, Richmond.)
Fig 2 Mucosal pemphigoid. There is a subepidermal blister containing eosinophils and lymphocytes.
Fig 3 Mucosal pemphigoid. Note the perivascular and interstitial infiltrate of lymphocytes, histiocytes, and conspicuous eosinophils.
Fig 4 Mucosal pemphigoid. Low-power view of oral lesion.
Fig 5 Mucosal pemphigoid. High-power view of blister cavity shown in Figure 4.
Fig 6 Mucosal pemphigoid. There is perivascular and interstitial lymphohistiocytic infiltrate with occasional plasma cells.
Fig 7 Mucosal pemphigoid. Biopsy specimen of an early oral lesion showing a cell-free subepidermal cleft.

This tumor is best visualized using PAS stains with and without diastase what is it?
1 Clear cell acanthoma
2 Seborrheic keratosis
3 Bowen’s disease
4 Tricholemmoma
5 Inverted follicular keratosis

Clear cell acanthoma is composed of pale staining keratinocytes that have increased glycogen content. The increased glycogen in this tumor is due to a defect in phosphorylase. Histologically the keratinocytes are mildly enlarged and pale and distinctly separated from the surrounding epidermis. The epidermis appears focally expanded by an acanthotic plate like growth that spares the follicular epithelium. Also associated with this tumor are PMNs that extend into the epidermis. There may be edema of the papillary dermal and some telangiectasis. PAS stain with and without diastase highlights the abundant glycogen.
Histology
Immunopathology/special stains
Main differential diagnoses
Fig 1 Clear cell acanthoma. There is parakeratosis, psoriasiform hyperplasia, and epidermal pallor.
Fig 2 Clear cell acanthoma. There is an intracorneal pustule. The keratinocytes have pale-staining cytoplasm. There is no atypia.
Fig 3 Clear cell acanthoma. The clear cells are strongly positive for glycogen as seen in this PAS stain.

A skin biopsy shows numerous fibroblasts with fibrosis and thickening of the dermis. There is sparse mucin deposition and on low power the biopsy appears square. Which of the following paraproteins would you expect to find in this patient?
1 IgG lambda
2 IgA
3 IgM
4 IgG kappa
5 IgA gamma
IgG lambda
The description of the biopsy above is that of scleromyxedema. These patients have an associated IgG lambda paraprotein. Other IgG subtypes may occur but lambda is most common. Scleromyxedema is a subset of lichen myxedematosus (papular mucinosis). It will present with coalescent erythematous to yellow papules and plaques. The most common location is the face, but will occur in many other locations. The surrounding skin is usually sclerodermoid in appearance. (Bolognia, p648-9)
Clinical features
Epidemiology
Presentation
Prognosis and treatment
Pathology
Histology
Immunopathology/special stains
Main differential diagnoses
Fig 1 Lichen myxedematosus. Low-power view showing separation of the dermal collagen fibers in the middle and on the left side. Toward the right, fibrosis is evident, suggesting transition to scleromyxedema.
Fig 2 Lichen myxedematosus. A light perivascular lymphocytic infiltrate is present. Increased numbers of spindled cells are seen.
Fig 3 Lichen myxedematosus. Fine, wispy strands of mucin are seen in this alcian blue preparation.

Which of the following shows granular deposition of IgA in the dermal papillae and along the basement membrane zone on direct immunoflourescence:
1 IgA pemphigus
2 Bullous pemphigoid
3 Linear IgA dermatosis
4 Dematitis herpetiformis
5 Herpes gestationalis
Dematitis herpetiformis
Dermatitis herpetiformis or Duhring’s disease, presents with very pruritic vesicles symmetrically on extensor surfaces. On histology it presents as suprapapillary vesicles with mostly neutrophils and inflammatory destruction of the basement membrane zone. Direct immunoflourescence shows granular deposition of IgA in the dermal papillae and along the basement membrane zone.

Acantholysis is not a prominent histopathologic feature of which disease?
1 Dermatitis herpetiformis
2 Darier’s disease
3 Grover’s disease
4 Pemphigus vulgaris
5 Hailey-Hailey diesease
Dermatitis herpetiformis is a bullous disease that on histology shows neutrophils in the dermal papillae. On direct immunoflourescence IgA is seen in a granular depostion pattern. Acantholysis is seen histologicaly in Darier’s disease, Grover’s disease, Pemphigus vulgaris, Hailey-Hailey disease and warty dyskeratoma.
Q/Q(M)-479628 Report a Problem
The predominant cleft in dermatitis herpetiformis is:
1 Dermal
2 Basement membrane zone
3 Basal keratinocytes
4 Suprabasal
5 Subcorneal/granular
Basement membrane zone
Dermatitis herpetiformis or Duhring’s disease, presents with very pruritic vesicles symmetrically on extensor surfaces. On histology it presents as suprapapillary vesicles with mostly neutrophils and inflammatory destruction of the basement membrane zone. Direct immunoflourescence shows granular deposition of IgA in the dermal papillae and along the basement membrane zone. The cleft in dermatitis herpetiformis is most commonly found in the basement membrane zone/subepidermal. The antigen is transglutaminase.
Q/Q(M)-479695 Report a Problem
Caterpillar bodies are seen in:
1 Lipoid proteinosis
2 Amyloidosis
3 Porphyria cutanea tarda
4 Mucocele
5 Dyskeratosis congenital
Porphyria cutanea tarda
Caterpillar bodies are thought to be type IV collagen.
Clinical features
Epidemiology
Presentation
Prognosis and treatment
Pathology
Histology
Immunopathology/special stains
Main differential diagnoses
Fig 1 Porphyria cutanea tarda. Vesicles, erosions, and scarring on the dorsal hands.
Fig 2 Porphyria cutanea tarda. Scanning view of a subepidermal blister.
Fig 3 Porphyria cutanea tarda. The blister cavity is cell free. Note the festooning.
Fig 4 Porphyria cutanea tarda. The presence of erythrocytes in the lumen of the blister is a common finding.
Fig 5 Porphyria cutanea tarda. The blood vessels are thickened, and there is a background of solar elastosis.
Fig 6 Porphyria cutanea tarda. High-power view highlighting blood vessel wall hyalinization.
Fig 7 Porphyria cutanea tarda. The thickened blood vessel walls can be emphasized by direct immunofluorescence, in this example with C3. Note focal deposition along the dermal–epidermal junction as well.

Multiple dermatofibromas are seen in:
1 Cowden’s
2 Lobomycosis
3 Incontinentia pigmenti
4 Lupus erythematosus
5 Reticulohistiocytosis
Multiple dermatofibromas are seen in lupus erythematosus and immunosuppression/HIV.
This is considered to be the juvenile counterpart of DFSP:
1 Juvenile hyaline fibromatosis
2 Giant cell fibroblastoma
3 Myxofibrosarcoma
4 Myofibromatosis
5 Plexiform fibrous histiocytoma
Giant cell fibroblastoma
An entity called giant cell fibroblastoma is CD34-positive, is mostly seen in male children on the neck/trunk, and is thought to be a juvenile counterpart of DFSP.
Clinical features
Epidemiology
Presentation
Prognosis and treatment
Pathology
Histology
Immunopathology/special stains
Main differential diagnosis
• Once the lumina are shown to be pseudovascular, there is no real differential diagnosis
Fig 1 Giant cell fibroblastoma. This view shows an admixture of spindled and multinucleate giant cells with pseudovascular spaces.
Fig 2 Giant cell fibroblastoma. Giant cells have multiple hyperchromatic nuclei.
Fig 3 Giant cell fibroblastoma. The pseudovascular spaces are focally lined by giant cells.

Histologically, adenoma sebaceum represent which of the following lesions?
1 Neurofibromas
2 Angiofibromas
3 Collagenomas
4 Angiokeratomas
5 Smooth muscle hamartomas
Angiofibromas
Adenoma sebaceum, fibrous papules and pearly penile papules all have similar features histologically, presenting as angiofibromas. Features include atrophic epidermis with patchy melanocytic hyperplasia and hyperkeratosis, vertically oriented collagen, increased fibroblasts and blood vessels.
Clinical features
Epidemiology
Presentation
Prognosis and treatment
• Generally no treatment is required, but the lesion is often removed when basal cell carcinoma is suspected clinically
Pathology
Histology
Immunopathology/special stains
Main differential diagnoses
Fig 1 Fibrous papule. Firm, dome-shaped, whitish-pink papule on the alar rim.
Fig 2 Fibrous papule. Shave biopsy showing increased vascularity and hypercellularity.
Fig 3 Fibrous papule. High-power view showing characteristic atypical myofibroblasts.
Fig 4 Fibrous papule. In this example, there is melanocytic hyperplasia in the overlying epidermis. This should not be mistaken for an atypical melanocytic proliferation or lentigo maligna.
Fig 5 Fibrous papule. The lesional cells express factor XIIIa.
Fig 6 Fibrous papule. There is focal CD34 expression.
Fig 7 Fibrous papule. S100 protein is negative in lesional cells.

Which of the following stains is specific for melanin?
1 S-100
2 HMB-45
3 Fontana-Masson
4 MART-1
5 Melan-A
Fontana-Masson is a silver stain and stains melanin black. S-100, HMB 45, MART-1 (Melan-A) are melanocyte stains. S-100 also decorates Langerhans cells, acrosyringium, and neural crest-derived cells.
Q/Q(M)-478119 Report a Problem
What are these organisms?
1 Leishmania
2 Trichosporon beigelii
3 Sporothrix schenckii
4 Penicillium marneffei
5 Histoplasmosis capsulatum
Leishmaniasis: Three main types: cutaneous (L tropica and mexicana), mucocutaneous (L. brasiliensis) and visceral/kala-azar (L donovani). Old world Leishmania (L tropica-major, minor and aethiopica) transmitted by Phlebotomus sandfly, new world (L mexicana, brasiliensis) transmitted by Lutzomyia sandfly. The promastigote lies in the sandfly is transmitted to humans and the amastigote infects macrophages. Macrophages become engorged with the organisms, but there is abnormal intracellular killing. Histology: Epidermis may display PEH and there is a dense dermal infiltrate consisting of foamy histiocytes, aka Leishman-Donovan bodies, with intracellular amastigotes along with epithelioid monocytes, giant cells, plasma cells and lymphocytes, variable eosinophils and PMNs. Organisms stain better with Giemsa, have a paranuclear kinetoplast and typically are located at periphery of macrophage, i.e. the Marquee sign. Can also see organism on skin slit smear. Older lesions show decreased organisms and tuberculoid granulomas may form.
Clinical features
Epidemiology
Presentation
Prognosis and treatment
Pathology
Histology
Immunopathology/special stains
• Giemsa stain demonstrates intracellular organism and highlights kinetoplast
Main differential diagnoses
Fig 1 Leishmaniasis. Low-power view of a fairly acute lesion with incipient ulceration.
Fig 2 Leishmaniasis. There is necrosis and abscess formation.
Fig 3 Leishmaniasis. There is an intense histiocytic infiltrate in the superficial dermis.
Fig 4 Leishmaniasis. Very high-power view showing amastigotes surrounded by a clear space.
Fig 5 Leishmaniasis. Low-power view of a chronic lesion showing a widespread granulomatous infiltrate.
Fig 6 Leishmaniasis. There is an admixture of plasma cells and histiocytes.
Fig 7 Leishmaniasis. High-power view of granuloma.
Fig 8 Leishmaniasis. Numerous intracellular amastigotes are seen in the superficial dermis.

Steatocystoma multiplex is associated with:
1 Jadassohn-Lewandowsky
2 Jackson-Lawler
3 Schaufer-Brunauer
4 Zinsser-Engman-Cole
5 Touraine-Solente-Gole
Jackson-Lawler (Jackson-Sertoli) is known as pachyonychia congenital type 2. Multiple steatocysts can be seen in this condition.
Clinical features
Epidemiology
Presentation
Prognosis and treatment
Pathology
Histology
Immunopathology/special stains
• Keratins 17 and 10 positive (see Eruptive Vellus Hair Cyst)
Main differential diagnoses
Fig 1 Steatocystoma. Scanning view showing a thin-walled empty cyst.
Fig 2 Steatocystoma. The stratified squamous epithelium has an inner, undulating hyaline cuticle.
Fig 3 Steatocystoma. The presence of a sebaceous gland adjacent to or in the cyst wall is a diagnostic feature.

This was excised from the face, what is this neoplasm ?
1 Syringoma
2 Trichoadenoma
3 Basal cell carcinoma
4 Desmoplastic trichoepithelioma
5 Microcystic adenocarcinoma

Syringomas on the eyelids, cheeks, chests and can be eruptive and increased numbers in Down’s syndrome and a clear cell change has been associated with diabetes. Histologically this is a dermal tumor consisting of eccrine ducts, lined by two cell layers sometimes creating a tad pole appearance, there can also be small basaloid islands or strands of cells. Within the lumens of the ducts is eosinophilic material, the lumens are CEA+. The tumor is located superficially and fails to display perineural extension as is seen in MAC. The glands are associated with a fibrous sclerotic stroma, usually no (or minimal) keratin cysts or foreign body granulomas as seen in desmoplastic trichoepithelioma. Enlargement of the glandular cells more of a clear or vacuolated cytoplasm can be seen in patients with diabetes.
Clinical features
Epidemiology
Presentation
Prognosis and treatment
Pathology
Histology
Immunopathology/special stains
Main differential diagnoses
Fig 1 Syringoma. Typical low-power appearance of epithelial strands and tubules in a dense fibrous stroma.
Fig 2 Syringoma. There are well-formed tubules, some with attached attenuated epithelial strands—the so-called tadpole appearance.
Fig 3 Syringoma. The epithelial cells are uniform. Note the intracytoplasmic lumina.

Stromelysin 3 is a negative marker for which of the following?
1 Dermatofibroma
2 Basal cell carcinoma
3 Dermatofibromasarcoma protuberans
4 Squamous cell carcinoma
5 Breast carcinoma
Stromelysin 3 is a negative marker which helps to distinguish dermatofibrosarcoma protuberans from dermatofibromas. Stromelysin 3 is a metalloproteinase which is expressed tissue remodeling. In a study performed by Cribier et.al. 100% of dermatofibromas stained positive Stromelysin 3 (ST3) is a member of the metalloproteinase family, which is expressed in tissue remodeling processes such as scarring, embryogenesis, or tumoral invasion.
Definition
• A low-grade malignant fibroblastic tumor of young adults characterized by a monotonous storiform growth pattern
Clinical features
Epidemiology
• Predilection for young adults
Presentation
Prognosis and treatment
Pathology
Histology
Immunopathology/special stains
Main differential diagnoses
Fig 1 Dermatofibrosarcoma protuberans. Low-power view showing a diffuse spindled cell tumor.
Fig 2 Dermatofibrosarcoma protuberans. At this magnification, the classical storiform growth pattern is well demonstrated.
Fig 3 Dermatofibrosarcoma protuberans. Mitoses as seen in the center of the field are generally uncommon.
Fig 4 Dermatofibrosarcoma protuberans. Pigmented dendritic cells and melanophages characterize the Bednar tumor variant.
(Courtesy of E Calonje, MD; St John’s Institute of Dermatology, London.)
Fig 5 Dermatofibrosarcoma protuberans. This is a high-power view showing fibrosarcomatous transformation. Note the fascicular growth pattern, nuclear pleomorphism, and mitotic figure.
(Courtesy of E Calonje, MD; St John’s Institute of Dermatology, London.)
Fig 6 Dermatofibrosarcoma protuberans. Occasionally, excessive mucin deposition is a feature. Usually, more typical features are evident elsewhere in the lesion.
Fig 7 Dermatofibrosarcoma protuberans. Exceptionally smooth muscle differentiation is seen—the myoid variant.
(Courtesy of E Calonje, MD; St John’s Institute of Dermatology, London.)
Fig 8 Dermatofibrosarcoma protuberans. The tumor cells show uniform expression for CD34.

Subcutaneous fat necrosis of the newborn has been associated with:
1 Hypocalcemia
2 Hypercalcemia
3 Hypokalemia
4 Hyperkalemia
5 Hyponatremia
Hypercalcemia has been noted in some cases of subcutaneous fat necrosis of the newborn.
Eosinophilia-Myalgia syndrome is caused by:
1 Norwegian salt-petter
2 Unadultered Spanish grapeseed oil
3 Pb intoxication
4 L-Tryptophan
5 Excessive anaerobic exercise
L-Tryptophan
The eosinophilia myalgia syndrome is characterized by marked peripheral eosinophilia with a clinical spectrum of signs and symptoms, including generalized myalgias, pneumonitis, myocarditis, neuropathy, encephalopathy and fibrosis. Many patients progress to a clinical picture clinically indistinguishable from eosinophilic fasciitis. The disease is caused by the ingestion of certain lots of L-tryptophan.
Which of the following immunohistochemical stains can help distinguish basal cell carcinomas and trichoepitheliomas from microcystic adnexal carcinomas?
1 Pro-collagen 1
2 CD34
3 Peanut agglutinin
4 TTF-1
5 Ber-Ep4
Ber-Ep4 helps distinguish between BCCs/Trichoepitheliomas and microcystic adnexal carcinomas. Morpheaform BCC and desmoplastic trichoepithelioma are Ber-Ep4 positive where as microcystic adnexal carcinomas (MAC) are Ber-Ep4 negative. Other markers that help distinguish between BCCs and trichoepitheliomas are peanut agglutinin and CD34. Peanut agglutinin is positive in BCC and negative in trichoepithelioma vs CD34 which is negative in BCC and positive in the peritumoral fibroblasts of trichoepitheliomas.
Silver preferentially deposits in:
1 Eccrine glands
2 Apocrine glands
3 Hair follicles
4 Fat
5 Eccrine glands and apocrine glands
Type 2 minocycline pigmentation. Has what type of granules?
Type 2 minocycline pigmentation stains positive with________.
Type 3 minocycline pigmentation stains positive with ____.
Amiodarone pigmentation is found at what location and what cell is present?
Eccrine glands
Argyria can look like normal skin if you do not notice the silver (black) deposits in the eccrine glands in the deep dermis.
Clinical features
Epidemiology
Presentation
Prognosis and treatment
Immunopathology/special stains
Main differential diagnoses
Fig 1 Type 2 minocycline pigmentation. Note the golden-brown pigment granules.
Fig 2 Type 2 minocycline pigmentation. Perl’s Prussian blue stain is positive.
Fig 3 Type 3 minocycline pigmentation. Masson-Fontana stain is positive.
Fig 4 Amiodarone pigmentation. Perivascular pigment-rich macrophages are present.
Fig 5 High-power view showing amiodarone pigmentation.
Fig 6 Argyria. Speckled black pigmentation present along the eccrine gland basement membrane.

The cytoplasmic granules seen in granular cell tumor are:
1 Phagolysosomes
2 Ribosomes
3 Mitochondria
4 Intermediate filaments
5 Vacuoles
The granules in granular cell tumor are phagolysosomes. The granularity of the granular cell layer in epidermodysplasia verruciformis may be secondary to increased ribosomes. Mitochondria fill the cells in hibernoma.
Granular Cell Tumor
Definition
• A neuroectodermal tumor characterized by S100-positive tumor cells containing lysosomal granules
Clinical features
Epidemiology
Presentation
Prognosis and treatment
Pathology
Histology
Immunopathology/special stains
Main differential diagnoses
Fig 1 Granular cell tumor. Part of an ulcerated lesion showing pseudoepitheliomatous hyperplasia.
Fig 2 Granular cell tumor. The tumor cells are large with abundant eosinophilic cytoplasm and uniform vesicular nuclei.
Fig 3 Granular cell tumor. Eosinophilic, intracytoplasmic inclusions are also a common feature.
Fig 4 Granular cell tumor. Very occasional pleomorphic nuclei are sometimes seen and in the absence of other features of malignancy are of no consequence.
Fig 5 Granular cell tumor. Very occasional normal mitotic figures are sometimes present.
Fig 6 Granular cell tumor. Perineural infiltration is often seen but is of no clinical significance.
Fig 7 Granular cell tumor. There is strong and uniform S100 protein expression.

What is this neoplasm?
1 Pilomatricoma
2 Proliferating pilar tumor
3 Trichoepithelioma
4 Basal cell carcinoma
5 Eccrine acrospiroma

Pilomatrixoma (Calcifying epithelioma of Malherbe): Found on the head, neck and upper extremities in the first 2 decades of life. Typically solitary but multiple pilomatricomas arise in several syndromes. Even in isolation these tumors may arise due to activating mutations in the beta-catenin gene. Histologically: This tumor consists of two major cell types plus an intermediate or transitional cell type. Initially the tumor is more cystic with the cells at the periphery of the tumor that are more basophilic with indistinct cell borders and little cytoplasm. The cells have hyperchromatic nuclei and often normal mitoses can be appreciated. Centrally there are eosinophilic “ghost or shadow†cells which are cells that have undergone terminal differentiation. These cells have more distinct borders, increased cytoplasm but only a ghost of a nucleus. Then there are cells that reside somewhere in between these two cell types. The proportion of these cells varies depending on the stage of the lesion; i.e younger lesions have more basophilic cells and appear more cystic, older lesions have a greater component of ghost cells and up to 20% of lesions on removal are completely composed of ghost cells.
Pilomatrixoma
Definition
• Benign adnexal tumor with differentiation toward the hair matrix
Clinical features
Epidemiology
Presentation
Prognosis and treatment
Pathology
Histology
Immunopathology/special stains
• Not contributory
Main differential diagnoses
Fig 1 Pilomatrixoma. Erythematous, firm nodule on the right temple of a girl.
Fig 2 Pilomatrixoma. Low-power view showing a circumscribed basophilic tumor surrounded by compressed fibrous tissue.
Fig 3 Pilomatrixoma. The basaloid cells have basophilic cytoplasm and regular oval or round vesicular nuclei with a prominent nucleolus. Note that there is brisk mitotic activity. This is a common feature and should not be taken to imply malignancy.
Fig 4 Pilomatrixoma. High-power view of typical eosinophilic anucleate “ghost” cells.
Fig 5 Pilomatrixoma. Stippled basophilic calcification is invariable in established lesions.
Fig 6 Pilomatrixoma. Many old lesions show bone formation sometimes accompanied by marrow spaces.
Fig 7 Pilomatrixoma. Scanning view of a circumscribed nodule.
(Courtesy of D Whittemore, DO; University of Texas, Houston.)
Fig 8 Pilomatrixoma. High-power view of basaloid cells showing vesicular nuclei and mitotic activity.
(Courtesy of D Whittemore, DO; University of Texas, Houston.)
Fig 9 Pilomatrixoma. Multinucleate giant cell are conspicuous.
(Courtesy of D Whittemore, DO; University of Texas, Houston.)
